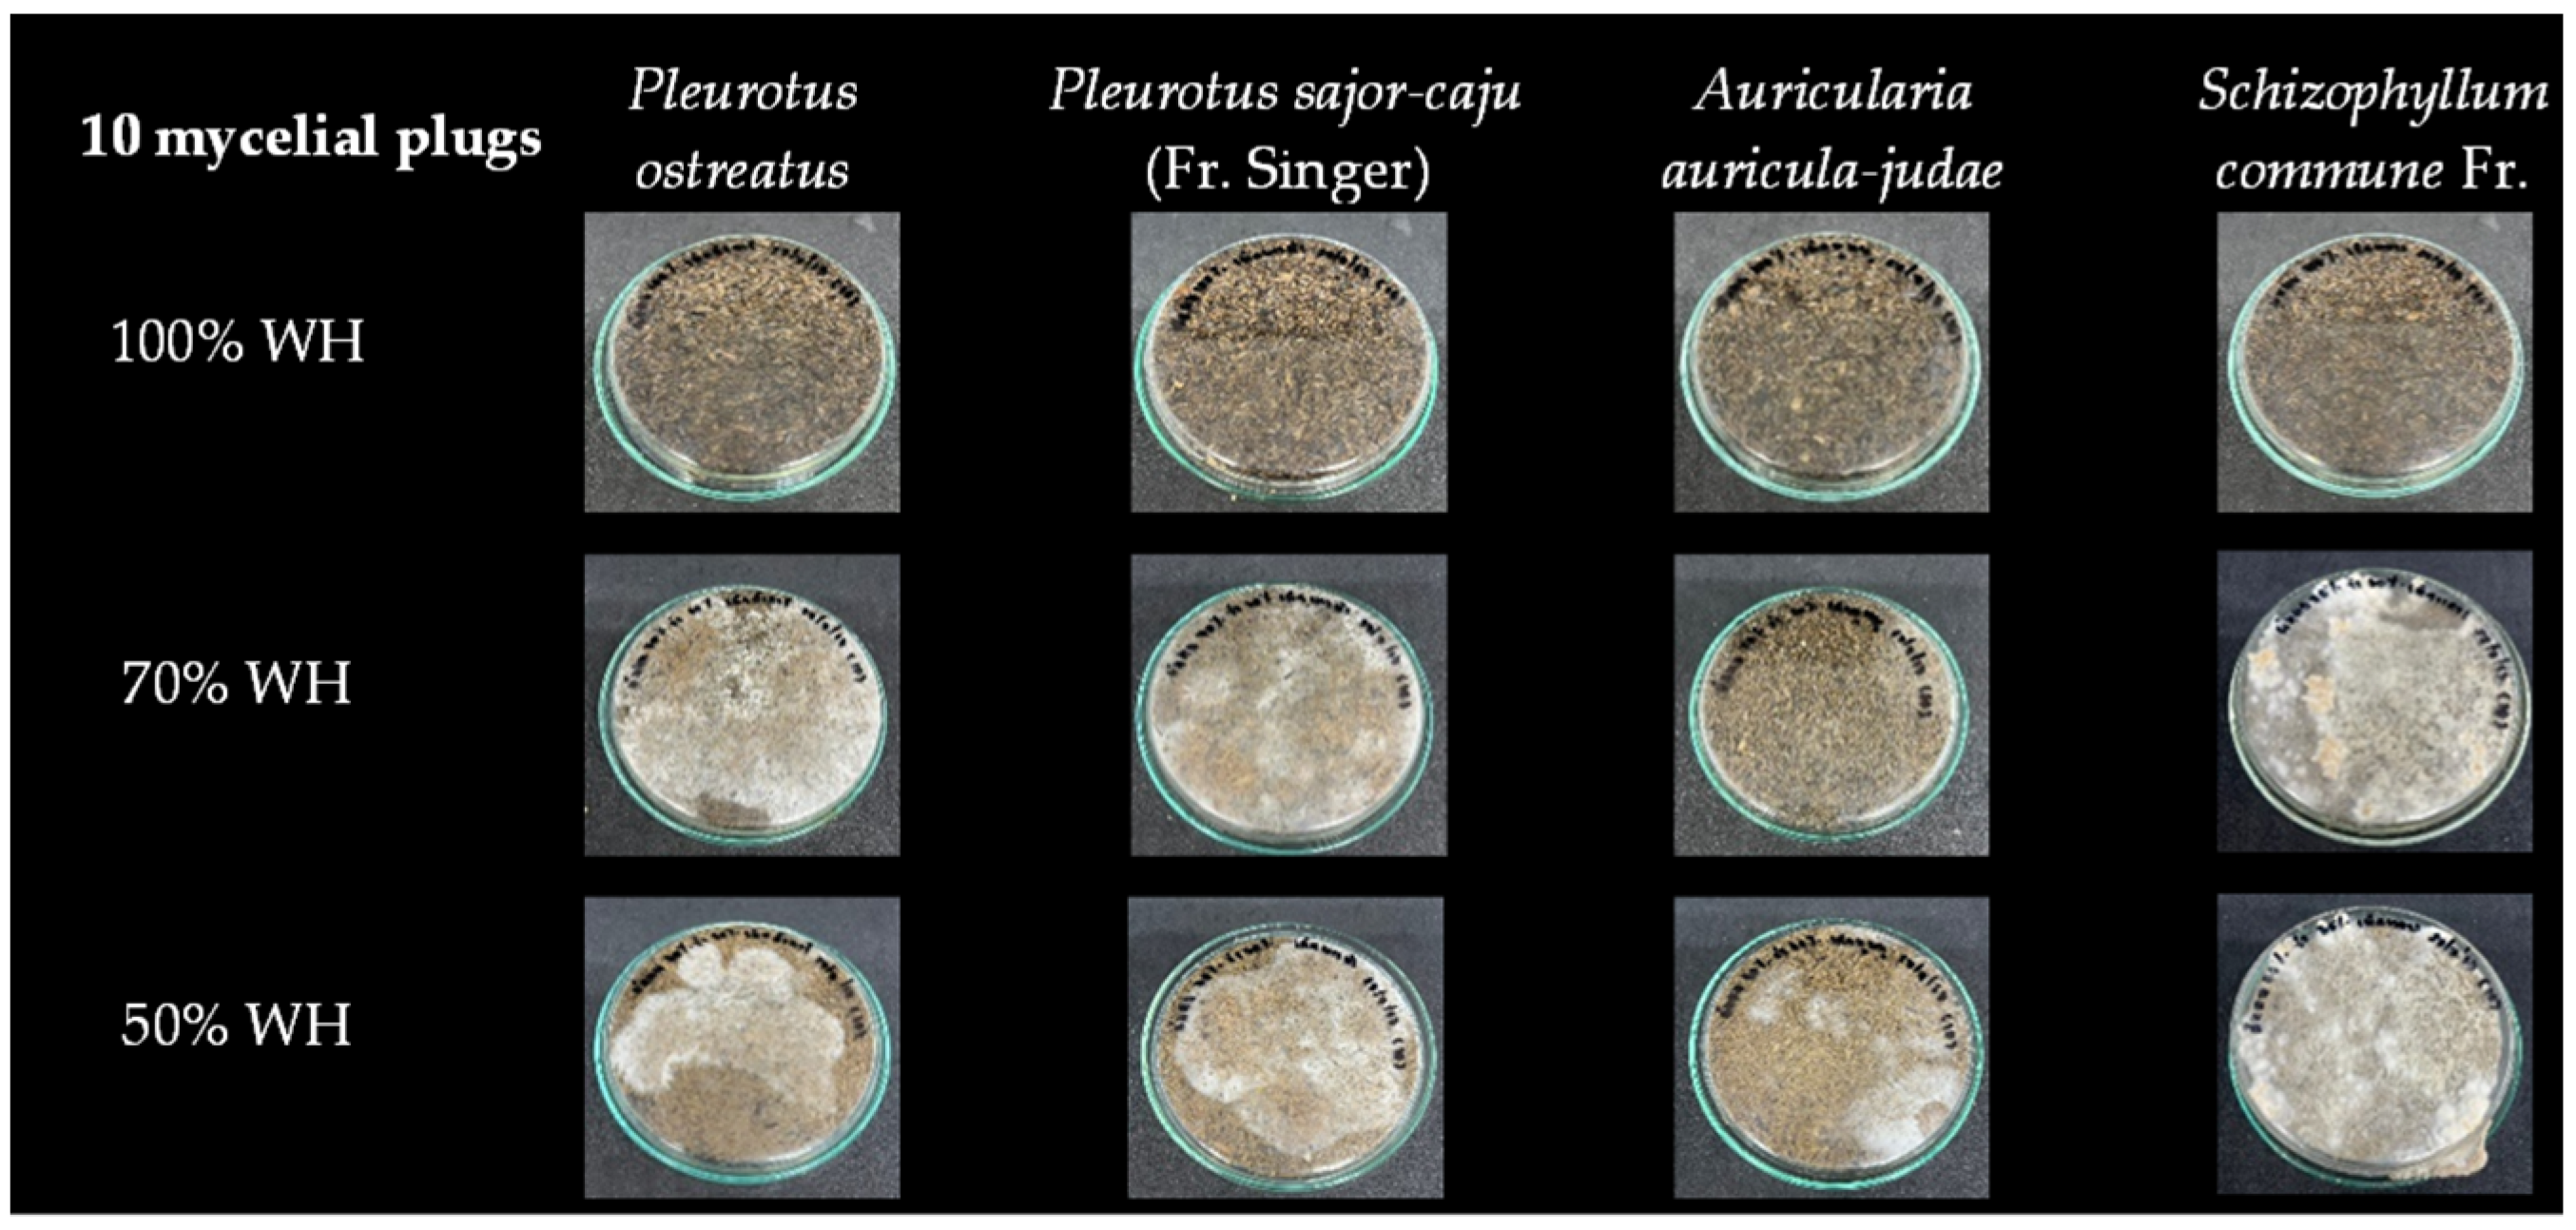
Coatings 14 00862 g001a

Characterization of Uncoated and Coated Fungal Mycelium-Based Composites from Water Hyacinth
Abstract
1. Introduction
2. Materials and Methods
2.1. Materials
2.1.1. Mushroom Species and Inoculum Preparation
2.1.2. Water Hyacinth and Rice Bran Preparation
2.2. Methods
2.2.1. Culture Conditions to Produce Mycelium-Based Composites
2.2.2. Preparation of Coating Solution and Composite Surface Coating
2.2.3. Physical and Mechanical Characterization
Physical Properties
Mechanical Properties
2.2.4. Morphologies of Uncoated and Coated Mycelial Composites
2.2.5. Determination of Biodegradation
3. Results and Discussion
3.1. Mycelial Growth Rates and Optimal Culture Temperature
3.2. Optimization of Composite Production Conditions
3.3. Physical and Mechanical Properties of Coated Mycelial Composites
3.4. Morphologies of Coated Mycelial Composites
3.5. Biodegradation of Uncoated Mycelial Composites and Chitosan-Solution-Coated Mycelial Composites
4. Conclusions
Author Contributions
Funding
Institutional Review Board Statement
Informed Consent Statement
Data Availability Statement
Acknowledgments
Conflicts of Interest
References
- Sydor, M.; Cofta, G.; Doczekalska, B.; Bonenberg, A. Fungi in Mycelium-Based Composites: Usage and Recommendations. Materials 2022, 15, 6283. [Google Scholar] [CrossRef] [PubMed]
- Soh, E.; Chew, Z.Y.; Saeidi, N.; Javadian, A.; Hebel, D.; Le Ferrand, H. Development of an extrudable paste to build mycelium-bound composites. Mater. Design. 2020, 195, 109058. [Google Scholar] [CrossRef]
- De Lima, G.G.; Schoenherr, Z.C.P.; Magalhães, W.L.E.; Tavares, L.B.B.; Helm, C.V. Enzymatic activities and analysis of a mycelium-based composite formation using peach palm (Bactris gasipaes) residues on Lentinula edodes. Bioresour. Bioprocess. 2020, 7, 58. [Google Scholar] [CrossRef]
- Aiduang, W.; Kumla, J.; Srinuanpan, S.; Thamjaree, W.; Lumyong, S.; Suwannarach, N. Mechanical, Physical, and Chemical Properties of Mycelium-Based Composites Produced from Various Lignocellulosic Residues and Fungal Species. J. Fungi 2022, 8, 1125. [Google Scholar] [CrossRef] [PubMed]
- Pohl, C.; Schmidt, B.; Nunez Guitar, T.; Klemm, S.; Gusovius, H.J.; Platzk, S.; Kruggel-Emden, H.; Klunker, A.; Völlmecke, C.; Fleck, C.; et al. Establishment of the basidiomycete Fomes fomentarius for the production of composite materials. Fungal Biol. Biotechnol. 2022, 9, 4. [Google Scholar] [CrossRef] [PubMed]
- Butu, A.; Rodino, S.; Miu, B.; Butu, M. Mycelium-based materials for the ecodesign of bioeconomy. Dig. J. Nanomater. Biostructures 2020, 15, 1129–1140. [Google Scholar] [CrossRef]
- Jones, M.P.; Mautner, A.; Luenco, S.; Bismarck, A.; John, S. Engineered Mycelium composite construction materials from fungal biorefineries: A critical review. Mater. Design. 2019, 187, 108397. [Google Scholar] [CrossRef]
- Manan, S.; Ullah, M.W.; Islam, M.; Atta, O.; Yang, G. Synthesis and Applications of Fungal Mycelium-based Advanced Functional Materials. J. Bioresour. Bioprod. 2021, 6, 1–10. [Google Scholar] [CrossRef]
- Yang, L.; Park, D.; Qin, Z. Material Function of Mycelium Based Bio-composite: A Review. Front. Mater. 2021, 8, 374. [Google Scholar] [CrossRef]
- Mohd Fairus, M.J.; Bahrin, E.; Natasha, E.; Arbaain, E.; Ramli, N. Mycelium-based Composite: A Way Forward for Renewable Material. J. Sustain. Sci. Manag. 2022, 17, 271–280. [Google Scholar] [CrossRef]
- Hotz, E.; Bradshaw, A.; Elliott, C.; Carlson, K.; Dentinger, B.; Naleway, S. Effect of Agar Concentration on Structure and Physiology of Fungal Hyphal Systems. J. Mater. Res. Technol. 2023, 24, 7614–7623. [Google Scholar] [CrossRef]
- Haneef, M.; Ceseracciu, L.; Canale, C.; Bayer, I.S.; Heredia-Guerrero, J.A.; Athanassiou, A. Advanced Materials From Fungal Mycelium: Fabrication and Tuning of Physical Properties. Sci. Rep. 2017, 7, 41292. [Google Scholar] [CrossRef] [PubMed]
- Kohphaisansombat, C.; Jongpipitaporn, Y.; Laoratanakul, P.; Antipaibulvut, S.; Euanorasetr, J.; Rungjindamai, N.; Chuaseeharonnachai, C.; Kwantong, P.; Somrithipol, S.; Boonyuen, N. Fabrication of mycelium (oyster mushroom)-based composites derived from spent coffee grounds with pineapple fibre reinforcement. Mycology 2023, 1–18. [Google Scholar] [CrossRef]
- Ismail, S.; Abdullah, A.S. Effect of using various substrates on cultivation of Pleurotus sajor-caju. J. Eng. Sci. Technol. 2017, 12, 1104–1110. [Google Scholar]
- Ly, L.; Jitjak, W. Biocomposites from agricultural wastes and mycelia of a local mushroom, Lentinus squarrosulus (Mont.) Singer. Open Agric. 2022, 7, 634–643. [Google Scholar] [CrossRef]
- Sornvoraweat, B.; Kongkiattikajorn, J. Separated hydrolysis and fermentation of water hyacinth leaves for ethanol production. KKU Res. J. 2010, 15. [Google Scholar]
- Okewale, A. Alternative energy production for environmental sustainability. Br. J. Renew. Energy 2016, 1, 18–22. [Google Scholar]
- Gunja, V.G.; Priyanka, J.; Sharma, S.C.; Dixit, A.; Jain, R. Production of bioethanol from water Hyacinth by isolated thermotolerant bacteria. Int. J. Curr. Sci. Technol. 2016, 4, 219–223. [Google Scholar]
- Das, S.P.; Gupta, A.; Das, D.; Goyal, A. Enhanced bioethanol production from water hyacinth (Eichhornia crassipes) by statistical optimization of fermentation process parameters using Taguchi orthogonal array design. Int. Biodeterior. Biodegrad. 2016, 109, 174–184. [Google Scholar] [CrossRef]
- Shah, F.; Mahmood, Q.; Pervez, A.; Rashid, N.; Shah, M.; Iqbal, A. Anaerobic Digestion of Water Hyacinth, Giant Reed, Maize and Poultry Waste for Biogas Generation. EC Agric. 2015, 2, 277–284. [Google Scholar]
- Onchonga, N.A.; Oima, D.; Oginda, D. Utilization of water hyacinth as an alternative substrate for mushroom farming: A study of vihiga mushroom project in western kenya. Int. J. Educ. Res. 2013, 1, 1–10. [Google Scholar]
- Lindsey, K.; Hirt, H. Use Water Hyacinth! A Practical Handbook of Uses for the Water Hyacinth from across the World; Anamed: Winnenden, Germany, 1999. [Google Scholar]
- Limpiteeprakan, P.; Khrueaphue, A.; Aomchat, A.; Tubtimhin, S.; Nganchamang, T. Development of Cushioning Materials from Water Hyacinth Fibers and Bagasse. Int. Conf. Solid Wastes 2023, 476–479. [Google Scholar]
- Mukhopadhyay, S. Oyster Mushroom Cultivation on Water Hyacinth Biomass: Assessment of Yield Performances, Nutrient, and Toxic Element Contents of Mushrooms; Intechopen: London, UK, 2019. [Google Scholar] [CrossRef]
- Nguyen, H.T.; Nguyen, T.B.H. Treatment of Water Hyacinth Fibers to Improve Mechanical and Microstructural Properties of Green Composite Materials. Nano Hybrids Compos. 2022, 35, 111–122. [Google Scholar] [CrossRef]
- Daengrot, C.; Rukachaisirikul, V.; Tansakul, C.; Thongpanchang, T.; Phongpaichit, S.; Bowornwiriyapan, K.; Sakayaroj, J. Eremophilane Sesquiterpenes and Diphenyl Thioethers from the Soil Fungus Penicillium copticola PSU-RSPG138. J. Nat. Prod. 2015, 78, 615–622. [Google Scholar] [CrossRef] [PubMed]
- Tudses, N. Isolation and Mycelial Growth of Mushrooms on Different Yam-based Culture Media. J. Appl. Biol. Biotechnol. 2016, 4, 33–36. [Google Scholar] [CrossRef]
- Iewkittayakorn, J.; Khunthongkaew, P.; Wongnoipla, Y.; Kaewtatip, K.; Suybangdum, P.; Sopajarn, A. Biodegradable plates made of pineapple leaf pulp with biocoatings to improve water resistance. J. Mater. Res. Technol. 2020, 9, 5056–5066. [Google Scholar] [CrossRef]
- ASTM D3574-95; Standard Test Methods for Flexible Cellular Materials—Slab, Bonded, and Molded Urethane Foams. ASTM International: West Conshohocken, PA, USA, 2001.
- ASTM D570-98; Standard Test Method for Water Absorption of Plastics. ASTM International: West Conshohocken, PA, USA, 2022.
- Joshi, K.; Meher, M.K.; Poluri, K.M. Fabrication and Characterization of Bioblocks from Agricultural Waste Using Fungal Mycelium for Renewable and Sustainable Applications. ACS Appl. Bio. Mater. 2020, 3, 1884–1892. [Google Scholar] [CrossRef] [PubMed]
- Ong, S.Y.; Sudesh, K. Effects of Polyhydroxyalkanoate Degradation on Soil Microbial Community. Polym. Degrad. Stab. 2016, 131. [Google Scholar] [CrossRef]
- Sisti, L.; Gioia, C.; Totaro, G.; Erstichel, S.; Cartabia, M.; Camere, S.; Celli, A. Valorization of wheat bran agro-industrial byproduct as an upgrading filler for mycelium-based composite materials. Ind. Crops Prod. 2021, 170, 113742. [Google Scholar] [CrossRef]
- Pegler, D.N. Hyphal analysis of basidiomata. Mycol. Res. 1996, 100, 129–142. [Google Scholar] [CrossRef]
- Liu, B.T.; Zhu, G.Y.; Ding, P.J. The research progress of epoxy resin coating in building Waterproof. Adv. Mater. Res. 2013, 671–674, 1779–1782. [Google Scholar] [CrossRef]
- Ji, W.G.; Hu, J.M.; Zhang, J.Q.; Cao, C.N. Reducing the water absorption in epoxy coatings by silane monomer incorporation. Corros. Sci. 2006, 48, 3731–3739. [Google Scholar] [CrossRef]
- Angelova, G.; Brazkova, M.; Stefanova, P.; Blazheva, D.; Vladev, V.; Petkova, N.; Slavov, A.; Denev, P.; Karashanova, D.; Zaharieva, R.; et al. Waste Rose Flower and Lavender Straw Biomass—An Innovative Lignocellulose Feedstock for Mycelium Bio-Materials Development Using Newly Isolated Ganoderma resinaceum GA1M. J. Fungi 2021, 7, 866. [Google Scholar] [CrossRef] [PubMed]
- Arivendan, A.; T., W.J.J.; Irulappasamy, S.; Chris, B.N. Water hyacinth (EichhorniaCrassipes) polymer composites properties—Aquatic waste into successful commercial product. Metall. Mater. Eng. 2022, 28, 157–169. [Google Scholar] [CrossRef] [PubMed]
- Piotrowska-Kirschling, A.; Brzeska, J. The Effect of Chitosan on the Chemical Structure, Morphology, and Selected Properties of Polyurethane/Chitosan Composites. Polymers 2020, 12, 1205. [Google Scholar] [CrossRef]
- Román-Doval, R.; Torres-Arellanes, S.P.; Tenorio-Barajas, A.Y.; Gómez-Sánchez, A.; Valencia-Lazcano, A.A. Chitosan: Properties and Its Application in Agriculture in Context of Molecular Weight. Polymers 2023, 15, 2867. [Google Scholar] [CrossRef]

| Mushroom Species | Growth Rate (mm/day) | |
|---|---|---|
| At 25 °C | At 30 °C | |
| Pleurotus ostreatus | 0.61 ± 0.09 | 1.19 ± 0.06 |
| Pleurotus sajor-caju (Fr. Singer) | 0.79 ± 0.05 | 1.06 ± 0.08 |
| Auricularia auricula-judae | 0.41 ± 0.05 | 0.94 ± 0.07 |
| Schizophyllum commune Fr. | 1.17 ± 0.03 | 1.45 ± 0.92 |
| Type of Coating | Density (g/cm3) | Water Absorption (%) |
|---|---|---|
| Uncoated composite | 0.0389 ± 0.0016 | 50.05 ± 0.66 |
| Composite coated with starch solution | 0.0399 ± 0.0037 | 51.37 ± 2.09 |
| Composite coated with chitosan solution | 0.0475 ± 0.0029 | 53.32 ± 1.00 |
| Composites coated with epoxy resin | 0.0942 ± 0.0021 | 43.60 ± 0.73 |
Disclaimer/Publisher’s Note: The statements, opinions and data contained in all publications are solely those of the individual author(s) and contributor(s) and not of MDPI and/or the editor(s). MDPI and/or the editor(s) disclaim responsibility for any injury to people or property resulting from any ideas, methods, instructions or products referred to in the content. |
© 2024 by the authors. Licensee MDPI, Basel, Switzerland. This article is an open access article distributed under the terms and conditions of the Creative Commons Attribution (CC BY) license (https://creativecommons.org/licenses/by/4.0/).
Share and Cite
Sakunwongwiriya, P.; Taweepreda, W.; Luenram, S.; Chungsiriporn, J.; Iewkittayakorn, J. Characterization of Uncoated and Coated Fungal Mycelium-Based Composites from Water Hyacinth. Coatings 2024, 14, 862. https://doi.org/10.3390/coatings14070862
Sakunwongwiriya P, Taweepreda W, Luenram S, Chungsiriporn J, Iewkittayakorn J. Characterization of Uncoated and Coated Fungal Mycelium-Based Composites from Water Hyacinth. Coatings. 2024; 14(7):862. https://doi.org/10.3390/coatings14070862
Chicago/Turabian StyleSakunwongwiriya, Puangpetch, Wirach Taweepreda, Siwapong Luenram, Juntima Chungsiriporn, and Jutarut Iewkittayakorn. 2024. "Characterization of Uncoated and Coated Fungal Mycelium-Based Composites from Water Hyacinth" Coatings 14, no. 7: 862. https://doi.org/10.3390/coatings14070862
APA StyleSakunwongwiriya, P., Taweepreda, W., Luenram, S., Chungsiriporn, J., & Iewkittayakorn, J. (2024). Characterization of Uncoated and Coated Fungal Mycelium-Based Composites from Water Hyacinth. Coatings, 14(7), 862. https://doi.org/10.3390/coatings14070862

